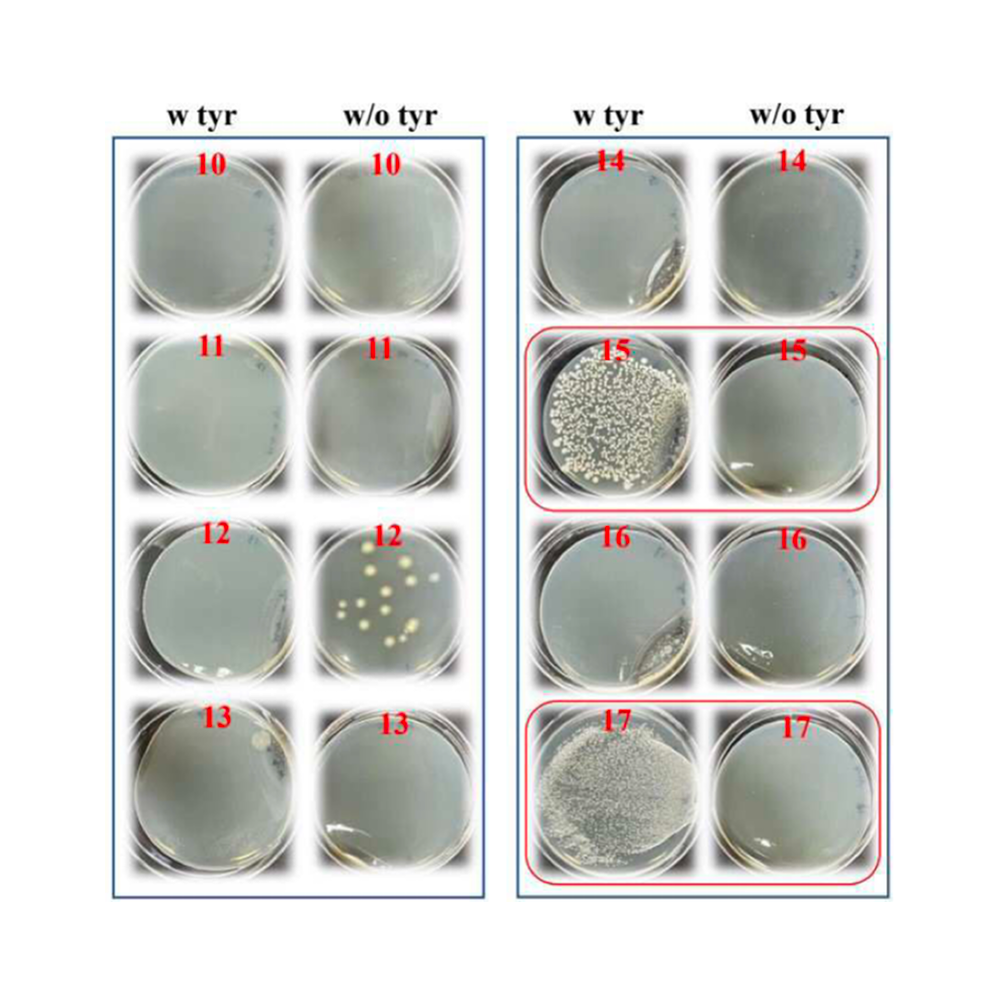

PIPELINES
연구 진척도
3대 질환 영역에서
자체 개발 8개 파이프라인 진행 중입니다.
Cosmetics
세라마이드-제인 복합체 나노입자

* 세라마이드-제인 복합체 나노입자, 이의 제조방법 및 이의 용도 (특허출원번호: 10-2023-0177328)
세라마이드(Ceramide)가 변성 제인 단백질(Zein protein)에 의해 캡슐화된 형태를 갖는 세라마이드-제인 복합체 나노입자를 제공. 세라마이드-제인 복합체 나노입자는 열처리에의해 3차원 구조가 변경된 변성 제인 단백질에 세라마이드가 캡슐화되어 있어서, 물(water)에 대한 용해도 또는 안정성이 우수. 세라마이드-제인 복합체 나노입자는 수상 제형이나 수분산제형과 같은 수계 환경을 갖는 화장품 소재로 매우 유용.
세라마이드(Ceramide)가 변성 제인 단백질(Zein protein)에 의해 캡슐화된 형태를 갖는 세라마이드-제인 복합체 나노입자를 제공. 세라마이드-제인 복합체 나노입자는 열처리에의해 3차원 구조가 변경된 변성 제인 단백질에 세라마이드가 캡슐화되어 있어서, 물(water)에 대한 용해도 또는 안정성이 우수. 세라마이드-제인 복합체 나노입자는 수상 제형이나 수분산제형과 같은 수계 환경을 갖는 화장품 소재로 매우 유용.
Cosmetics
섬기린초 추출물 탄수화물/단백질 나노 복합체

* 섬기린초 추출물 탄수화물 나노 복합체 및 이의 제조 방법 (특허등록번호: 10-2217554-0000)
* 섬기린초 추출물 단백질 나노 복합체 및 이의 제조 방법 (특허등록번호: 10-2127634-0000)
* Biotechnology Journal, 15, 2000080 (2020)
* 섬기린초 추출물 단백질 나노 복합체 및 이의 제조 방법 (특허등록번호: 10-2127634-0000)
* Biotechnology Journal, 15, 2000080 (2020)
Cosmetics
마이크로바이옴 화장품이란?

피부에 서식하는 미생물 군집(마이크로바이옴)의 균형을 회복하여, 피부 건강을 증진을 목표로 하는 화장품
피부 건강 및 장벽 강화:
피부 마이크로바이옴의 균형이 유지하여 피부 장벽이 강화하여 건강한 피부로 회복하고, 피부 트러블 개선
항노화 및 주름개선:
프로바이오틱스 성분은 피부 재생률을 높이고, 주름 개수와 깊이를 감소시켜 피부 리프팅 효과 제공
피부 마이크로바이옴의 균형이 유지하여 피부 장벽이 강화하여 건강한 피부로 회복하고, 피부 트러블 개선
항노화 및 주름개선:
프로바이오틱스 성분은 피부 재생률을 높이고, 주름 개수와 깊이를 감소시켜 피부 리프팅 효과 제공
Cosmetics
마이크로바이옴 화장품 시장 현황

로레알 그룹
랑콤의 제니피끄 시리즈로 마이크로바이옴 화장품 시장 선도하며, 16년간 마이크로바이옴 연구를 통해 5억 건 이상의 실험 데이터와 50여 편의 논문 발표
에스티로더
1982년 출시된 “어드밴스드 나이트 리페어(갈색병)”이 대표적인 프로바이오틱스 화장품은 주성분인 비피다발효용해물로 30여년간 명품 화장품 위치 유지
한국콜마
경희대, GFC 생명과학과 협력하여 20대 여성 피부 유래 프로바이오틱스 엑소좀 연구
락토바실러스 프란타룸 기반 안티에이징 화장품 개발
마녀공장
비피다 바이옴 콤플렉스 세럼으로 미국 코스트코 진출
에스티로더 갈색병 대체제로 주목 받고 있음
랑콤의 제니피끄 시리즈로 마이크로바이옴 화장품 시장 선도하며, 16년간 마이크로바이옴 연구를 통해 5억 건 이상의 실험 데이터와 50여 편의 논문 발표
에스티로더
1982년 출시된 “어드밴스드 나이트 리페어(갈색병)”이 대표적인 프로바이오틱스 화장품은 주성분인 비피다발효용해물로 30여년간 명품 화장품 위치 유지
한국콜마
경희대, GFC 생명과학과 협력하여 20대 여성 피부 유래 프로바이오틱스 엑소좀 연구
락토바실러스 프란타룸 기반 안티에이징 화장품 개발
마녀공장
비피다 바이옴 콤플렉스 세럼으로 미국 코스트코 진출
에스티로더 갈색병 대체제로 주목 받고 있음
Cosmetics
엘렉스랩은 여드름의 원인균인 C .acnes와
피부트러블 원인균 S. aureus을 조절하는
마이크로바이옴 치료제 후보 물질을
유산균 라이브러리+예쁜꼬마선충 모델 통해 발굴중입니다.
Functional Foods
GBLac™ 똑똑한 습관 프로바이오틱스
.jpg)

Functional Foods
프로바이오틱스 기반 L-DOPA 생산

* 유산균 및 L-티로신의 조합을 포함하는 파킨슨병 예방, 개선 또는 치료용 조성물 (특허등록번호: 10-2903891-0000)
본사에서 발굴한 락티플란티바실러스 플란타룸 균주, 락티플란티바실러스 파라플란타룸 균주, 락티플란티바실러스 펜토수스 유산균은 L-티로신의 레보도파로의 전환 활성이 매우 높다.
본사에서 개발한 특정 유산균 및 L-티로신을 포함하는 조성물은 생체내에서 레보도파를 생산할 수 있도록 제형화 될 수 있고, 파킨슨병의 예방, 개선 또는 치료를 위한 건강기능식품 또는 의약품으로 사용될 수 있다.
본사에서 발굴한 락티플란티바실러스 플란타룸 균주, 락티플란티바실러스 파라플란타룸 균주, 락티플란티바실러스 펜토수스 유산균은 L-티로신의 레보도파로의 전환 활성이 매우 높다.
본사에서 개발한 특정 유산균 및 L-티로신을 포함하는 조성물은 생체내에서 레보도파를 생산할 수 있도록 제형화 될 수 있고, 파킨슨병의 예방, 개선 또는 치료를 위한 건강기능식품 또는 의약품으로 사용될 수 있다.
Therapeutics
글라브리딘-제인 복합체 나노입자

* 글라브리딘-제인 복합체 나노입자, 이의 제조방법 및 이의 용도(특허등록번호: 10-1902846-0000)
* Food Hydrocolloids, 91, 290-300 (2019)
글라브리딘(Glabridin)이 제인 단백질(Zein protein)에 의해 캡슐화된 형태를 갖는, 글라브리딘-제인 복합체 나노입자. 수계 환경에서 글라브리딘의생리활성을 극대화시킬 수 있으므로 항산화, 항균 용도의 식품, 의약품 소재로 사용할 수 있다.
* Food Hydrocolloids, 91, 290-300 (2019)
글라브리딘(Glabridin)이 제인 단백질(Zein protein)에 의해 캡슐화된 형태를 갖는, 글라브리딘-제인 복합체 나노입자. 수계 환경에서 글라브리딘의생리활성을 극대화시킬 수 있으므로 항산화, 항균 용도의 식품, 의약품 소재로 사용할 수 있다.
Therapeutics
레보도파(L-DOPA) 바이오 전환 기술
* L-티로신으로부터 레보도파를 생산하는 방법 (특허등록번호: 10-2798366-0000)
유산균 및 L-티로신을 포함하는 조성물은 생체내에서 레보도파를 생산할 수 있도록 제형화될 수 있고, 파킨슨병의 예방, 개선 또는 치료를 위한 건강기능식품 또는 의약품으로 사용될 수 있다.
유산균 및 L-티로신을 포함하는 조성물은 생체내에서 레보도파를 생산할 수 있도록 제형화될 수 있고, 파킨슨병의 예방, 개선 또는 치료를 위한 건강기능식품 또는 의약품으로 사용될 수 있다.
지금 엘렉스랩에 1:1 상담을 받아보세요.
3영업일 이내에 답변드리겠습니다.
